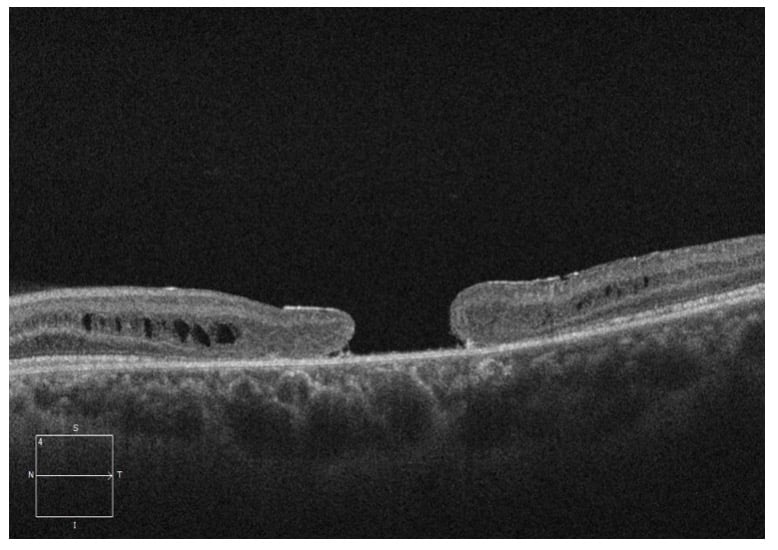

¹Department of Ophthalmology, St. Michael’s Hospital; Faculty of Medicine, University of Toronto, Toronto, Ontario, Canada

A 25-year-old male was referred for a second opinion of progressively worsening vision OU for the past 14 years. His ocular history was significant for previous diagnosis of macular hole OU as a child. The Fundus exam revealed bilateral large macular holes with yellow/brown pigmentation OU (figure 1). OCT (Optical Coherence Tomography) confirmed the full thickness macular holes with foveal retinoschisis OU (figure 2). Given the history of pediatric bilateral macular holes in absence of trauma, Electroretinogram (ERG) was performed, which showed decreased B-waves (negative ERG) in both eyes (figure 3), consistent with X-linked retinoschisis.
Unlike in the adult population, idiopathic macular holes in the pediatric population are extremely rare1. Macular holes in children are most commonly secondary to trauma and may spontaneously close2. In absence of risk factors, such as trauma or myopia, other etiologies should be considered, including X-linked retinoschisis1.